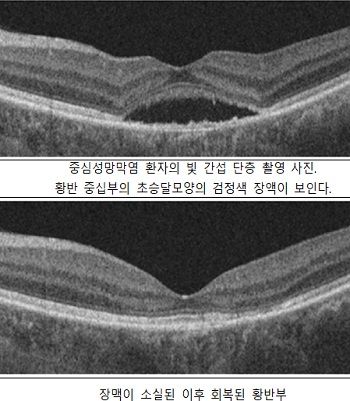

여의도성모 안과병원 노영정 교수팀이 중심성장액맥락망막병증(이하 중심성망막염, CSC) 치료를 위한 새로운 마이크로초레이저 치료법을 개발했다.
노영정 교수팀은 527nm 파장의 1.7 마이크로초레이저로 시세포 손상없이 망막색소상피세포에 선택적 미세응고를 일으킨 후, 색소상피세포의 증식을 통한 재생을 유도하는 치료법인 선택적망막치료술 (SRT)을 시행, 29명의 중심성망막염 환자를 치료했다.
레이저 치료부위 안저이미지 (fundus image-based) 분석 후 에너지를 조절한 후 황반부에 레이저 시술을 실시했다.
기존 선택적망막치료술에서는 마이크로초레이저의 파워만을 조절해 치료 했지만, 안저 이미지의 희미한 레이저 조사반을 분석해 추가적으로 마이크로초레이저 개수(number)를 조절하는 방법을 적용했다.
이는 망막색소상피를 선택적으로 치료하기 위해 더 세밀한 에너지 조절이 가능하다.
치료 후 3개월에 65.5%, 6개월에 89.7%(26명)의 환자에서 망막하액이 완전히 소실됐다. 10명(34.5%)에서 재치료가 필요했으나 레이저로 인한 중심암점 등 부작용은 발견되지 않았다.
중심성망막염 환자들은 자연치유가 되기도 하지만, 재발이 흔하고 50%이상은 만성으로 진행될 수 있다.
노영정 교수는 “표준치료법 부재로 만성으로 진행된 중심성망막염 환자들에게 시도할수 있는 치료법 선택에 어려움이 많았다.” 라며, “만성화된 중심성망막염은 임상양상에 매우 다양하여 유병기간이 경과할수록 치료가 어렵기에 발병 후 3개월내 자연치유가 되지 않으면 망막전문의 진료 및 치료가 중요하다.”라 고 밝혔다.
이번 연구에서는 노영정 교수가 가톨릭대학교 산학협력단을 통해 2022년 창업한 교원창업기업 (주)트레숄드(THRESHOLD Corp.)에서 출시한 안과용 레이저 의료기기 마큐포커스(MACUFOCUS) 레이저를 사용했다.
이 장비는 식품의약품안전처로부터 중심성망막염(CSC)과 당뇨병성황반부종(DME)에 대한 치료용으로 승인 받았다.
이번 연구결과는 SCIE급 국제 학술지인 임상의학저널(Journal of Clinical Medicine) 최신호에 발표했다.
한편 마이크로초레이저는 기존의 광응고 레이저보다 훨씬 짧은 시간 동안 방출된다.
일반 레이저의 10만분의 1초에 해당하는 짧은 시간 동안 방출되는 마이크로초레이저는 망막 조직의 온도 상승을 막아 시세포 손상 없이 장액 누출을 치료할 수 있다.
[메디컬월드뉴스 김영신 기자]
Copyright ⓒ 메디컬월드뉴스 무단 전재 및 재배포 금지